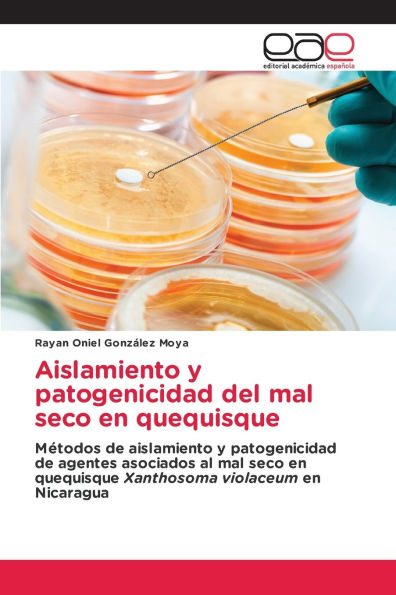
Aislamiento y patogenicidad del mal seco en quequisque

Home
TB Joshua El profeta mal entendido y tergiversado en SCOAN
Barnes and Noble
Loading Inventory...
TB Joshua El profeta mal entendido y tergiversado en SCOAN in Franklin, TN
Current price: $19.99

Barnes and Noble
TB Joshua El profeta mal entendido y tergiversado en SCOAN in Franklin, TN
Current price: $19.99
Loading Inventory...
Size: OS
Nunca un tiempo como nuestro tiempo ha tenido a la iglesia tan dividida en métricas diversas como ahora . Nos vemos como rivales en lugar de hermanos. Pasamos a o tanto tiempo discutiendo sobre la escritura, la derecha o la denominación incorrecta, doctrinas, credo, que es un hombre o una mujer de Dios y quién no lo es, que es un demonio y que es tan aint. La mayoría de los que se eligen por lo general solo tienen comunión con aquellos en su propia iglesia o grupo. Esta segregación es divisiva. En detrimento del mandato singular que Jesús le dio a cada creyente para salir y hacer discípulos de todas las naciones, enseñándoles a obedecer todo lo que Él nos ha ordenado. - Mateo 28: 19,20 .
Nunca un tiempo como nuestro tiempo ha tenido a la iglesia tan dividida en métricas diversas como ahora . Nos vemos como rivales en lugar de hermanos. Pasamos a o tanto tiempo discutiendo sobre la escritura, la derecha o la denominación incorrecta, doctrinas, credo, que es un hombre o una mujer de Dios y quién no lo es, que es un demonio y que es tan aint. La mayoría de los que se eligen por lo general solo tienen comunión con aquellos en su propia iglesia o grupo. Esta segregación es divisiva. En detrimento del mandato singular que Jesús le dio a cada creyente para salir y hacer discípulos de todas las naciones, enseñándoles a obedecer todo lo que Él nos ha ordenado. - Mateo 28: 19,20 .